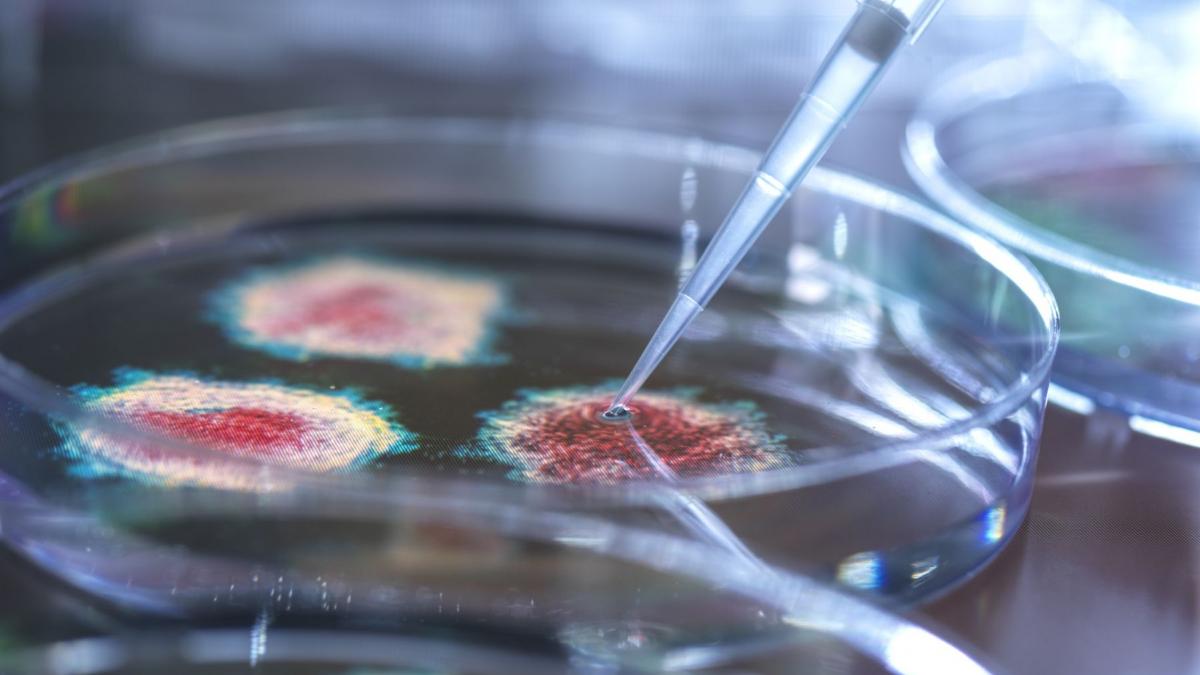
cercetare virus laborator getty images

O echipă de cercetători a făcut un pas istoric spre crearea unor forme de viață complet noi, dezvoltate în laborator. Oamenii de știință au folosit inteligența artificială pentru a proiecta un virus capabil să atace o colonie de bacterii E.coli, unele dintre cele mai periculoase pentru organismul uman, scrie Metro.
Cercetarea a fost realizată la Universitatea Stanford, în California, unde AI-ul a conceput integral genomul virusului, denumit Evo-Φ2147. Este pentru prima dată când un organism de acest tip este creat de la zero, pornind exclusiv de la calcule și algoritmi.
Descoperirea marchează un moment-cheie în biologia sintetică și ridică posibilitatea ca noi „specii” să fie aduse la viață direct din eprubetă.
„Este un moment uriaș, cu consecințe profunde”, a declarat pentru Sunday Times Adrian Woolfson, biolog molecular britanic și antreprenor în tehnologie. „Acum nu mai descoperim doar viața, ci începem să o creăm. Chiar dacă încă într-o formă primitivă, procesul a început. Nu vorbim despre un viitor îndepărtat, se întâmplă deja.”
Evo-Φ2147 este doar unul dintre cele 285 de virusuri proiectate de programul de inteligență artificială Evo2. Toate au fost testate în laborator, iar 16 dintre ele au reușit să atace bacteriile E.coli. Mai mult, o combinație a acestor 16 tulpini a reușit să distrugă chiar și cele mai rezistente variante ale bacteriei.
Deși nu poate fi considerat „viață” în sens deplin, deoarece virusul nu se poate reproduce fără o gazdă și conține doar 11 gene, față de cele aproximativ 20.000 ale omului, Evo-Φ2147 demonstrează un lucru esențial: genomurile pot fi proiectate complet, de la zero.
„Dacă poți controla codul-sursă al vieții, poți crea practic orice”
Genomul reprezintă setul complet de instrucțiuni genetice ale unui organism, informația care îi dictează dezvoltarea, funcționarea și reproducerea.
Woolfson și echipa sa de la compania Genyro sunt deja pionieri în acest domeniu. Cercetători din grupul său au contribuit și la dezvoltarea unui nou instrument de construcție a ADN-ului, prezentat recent în revista Nature.
Potrivit oamenilor de știință de la Institutul de Tehnologie din California, noua tehnologie, numită Sidewinder, permite construirea unor secvențe genetice extrem de lungi, cu o precizie de până la 100.000 de ori mai mare decât metodele existente până acum.
„Dacă poți controla codul-sursă al vieții, poți crea practic orice”, a explicat Kaihang Wang, unul dintre cercetători. „Singura limită reală este imaginația noastră.”
Combinate, aceste tehnologii ar putea declanșa o revoluție în medicină, în dezvoltarea de materiale noi. Woolfson crede că ele ar putea fi folosite inclusiv pentru a crea specii complet noi sau pentru a readuce la viață animale dispărute.
Cercetătorii spun că, dacă astfel de instrumente ar fi existat în timpul pandemiei de Covid-19, primul vaccin mRNA ar fi putut fi realizat în doar 62 de ore, nu în cele 42 de zile necesare în 2020.
Totuși, progresele vin la pachet cu riscuri majore. Woolfson subliniază nevoia de responsabilitate și control strict. De exemplu, modelul Evo2 nu a fost antrenat folosind virusuri periculoase pentru oameni.
„Omenirea trebuie să decidă cine stabilește limitele”, avertizează el. „Cine hotărăște ce poate fi creat? Cine stabilește regulile? Societatea trebuie să știe că aceste lucruri se întâmplă, pentru ca discuțiile să aibă loc acum, nu prea târziu.”